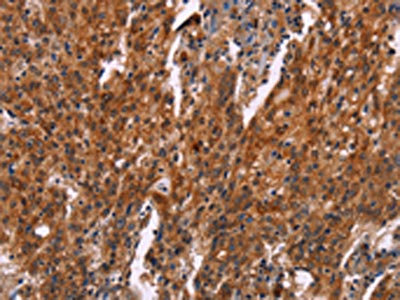

HSPB6 Antibody
-
中文名稱:HSPB6兔多克隆抗體
-
貨號:CSB-PA085605
-
規(guī)格:¥1100
-
圖片:
-
The image on the left is immunohistochemistry of paraffin-embedded Human thyroid cancer tissue using CSB-PA085605(HSPB6 Antibody) at dilution 1/30, on the right is treated with synthetic peptide. (Original magnification: ×200)
-
The image on the left is immunohistochemistry of paraffin-embedded Human gastric cancer tissue using CSB-PA085605(HSPB6 Antibody) at dilution 1/30, on the right is treated with synthetic peptide. (Original magnification: ×200)
-
-
其他:
產(chǎn)品詳情
-
Uniprot No.:
-
基因名:HSPB6
-
別名:epididymis luminal protein 55 antibody; FLJ32389 antibody; Heat shock 20 kDa like protein p20 antibody; Heat shock 20 kDa-like protein p20 antibody; Heat shock protein alpha crystallin related B6 antibody; Heat shock protein beta 6 antibody; Heat shock protein beta-6 antibody; Heat shock protein; 20-KD antibody; Heat-shock 27-KD protein 6 antibody; HEL55 antibody; Hsp20 antibody; HspB6 antibody; HSPB6_HUMAN antibody
-
宿主:Rabbit
-
反應(yīng)種屬:Human,Mouse,Rat
-
免疫原:Synthetic peptide of Human HSPB6
-
免疫原種屬:Homo sapiens (Human)
-
標記方式:Non-conjugated
-
抗體亞型:IgG
-
純化方式:Antigen affinity purification
-
濃度:It differs from different batches. Please contact us to confirm it.
-
保存緩沖液:-20°C, pH7.4 PBS, 0.05% NaN3, 40% Glycerol
-
產(chǎn)品提供形式:Liquid
-
應(yīng)用范圍:ELISA,IHC
-
推薦稀釋比:
Application Recommended Dilution ELISA 1:2000-1:5000 IHC 1:50-1:200 -
Protocols:
-
儲存條件:Upon receipt, store at -20°C or -80°C. Avoid repeated freeze.
-
貨期:Basically, we can dispatch the products out in 1-3 working days after receiving your orders. Delivery time maybe differs from different purchasing way or location, please kindly consult your local distributors for specific delivery time.
-
用途:For Research Use Only. Not for use in diagnostic or therapeutic procedures.
相關(guān)產(chǎn)品
靶點詳情
-
功能:Small heat shock protein which functions as a molecular chaperone probably maintaining denatured proteins in a folding-competent state. Seems to have versatile functions in various biological processes. Plays a role in regulating muscle function such as smooth muscle vasorelaxation and cardiac myocyte contractility. May regulate myocardial angiogenesis implicating KDR. Overexpression mediates cardioprotection and angiogenesis after induced damage. Stabilizes monomeric YWHAZ thereby supporting YWHAZ chaperone-like activity.
-
基因功能參考文獻:
- Structural basis for the interaction of a human HSPB6 protein with the 14-3-3 universal signaling regulator has been reported. PMID: 28089448
- Data suggest that HSPB6 forms hetero-oligomers with HSPB1 under the following rules: (1) highly conserved motif RLFDQXFG is necessary for subunit exchange among oligomers, (2) a site about 20 residues downstream of this motif determines size of resultant hetero-oligomers, and (3) a region in the N-terminal domain that is unique to HSPB6 dictates preferential formation of heterodimers. (HSP = heat shock protein) PMID: 28487364
- findings strongly suggest that phosphorylated HSP20 inhibits TGF-alpha-induced HCC cell migration and invasion via suppression of the JNK signaling pathway PMID: 27046040
- multiple sclerosis lesions revealed exclusive induction of HSPB6 in astrocytes, as confirmed by co-localization of HSPB6 with GFAP. PMID: 26694816
- N-terminal mutations increase stability of large HspB1 homooligomers, prevent their phosphorylation-dependent dissociation, modulate their interaction with HspB6 and decrease their chaperoning capacity, preventing normal functioning of HspB1. PMID: 25965061
- Findings strongly suggest that HSP20 directly associates with Bax and stimulates caspase cascade in human hepatocellular carcinoma cells. PMID: 24969689
- Data suggest that heat shock protein 20 (HSP20) may have value as a prognostic tumor marker and its overexpression might be a novel strategy for colorectal cancer (CRC) therapy. PMID: 25187324
- peptides in heat-shock protein Hsp20 (G71HFSVLLDVKHFSPEEIAVK91) and Hsp27 (D93RWRVSLDVNHFAPDELTVK113) with sequence homology to alpha-crystallin also have robust chaperone and anti-apoptotic activities. PMID: 25332102
- These findings strongly suggest that HSP20 might decrease the IKK-alpha protein level and that it down-regulates the TNF-alpha-stimulated intracellular signaling in HCC, thus resulting in the suppression of HCC progression. PMID: 25447820
- HSP20 may play a protective role against the progression of ovarian cancer. PMID: 25423708
- HSP20 directly associates with PI3K subunits and suppresses its activity in hepatocellular carcinoma, resulting in the inhibition of the AKT pathway, and subsequently decreasing the growth of hepatocellular carcinoma. PMID: 24223153
- 14-3-3zeta and possibly other 14-3-3 isoforms may have additional functional roles conducted by the monomeric state PMID: 22794279
- the cytosolic protein AKAP-Lbc (AKAP13) as the anchoring protein responsible for directing PKA phosphorylation of Hsp20 on Ser(16) PMID: 22731613
- Hsp20 serves as a novel cardiokine in regulating myocardial angiogenesis through activation of the VEGFR signaling cascade. PMID: 22427880
- cofilins 1 and 2 only weakly interact with 14-3-3 and therefore cannot directly compete with phosphorylated small heat shock protein HspB6 for its binding to 14-3-3 PMID: 22450169
- Properties of the monomeric form of 14-3-3zeta protein and its interaction with tau and HspB6. This interaction requires phosphorylation of tau protein and HspB6. PMID: 21978388
- A potential molecular mechanism by which Hsp20 acetylation can affect myometrial activity by liberating cofilin PMID: 21803775
- Overexpression of HSPB1, as well as HSPB6, HSPB7 and HSPB8 independently protect against tachycardia remodeling by attenuation of the RhoA GTPase pathway at different levels. PMID: 21731611
- Nevertheless, in solution, both alpha-crystallin domain proteins form stable dimers via the symmetric antiparallel interaction of beta7 strands. PMID: 21641913
- The 14-3-3 zeta mutation mimicking phosphorylation of Ser184 does not markedly affect interaction with tau protein and improves the interaction of 14-3-3 zeta with HspB6. PMID: 21081103
- Data show that the interaction between HspB6 and Bag3 requires the same regions that are involved in the HspB8-Bag3 association. PMID: 19845507
- Our results suggest that a variety of oligomers composed of different proportions of different sHSPs may form in cell types expressing multiple sHSPs. PMID: 16225851
- Phosphorylation led to changes in actin cytoskeletal morphology in 3T3 cells, delineating strategies for the expression and activation of therapeutic molecules for intracellular protein based therapeutics. PMID: 17084643
- Interaction of human 14-3-3gamma with the small heat shock protein Hsp20 was analyzed by means of size-exclusion chromatography and chemical crosslinking. PMID: 17109079
- Data support a novel role for pHSP20 in the modulation of cyclic-nucleotide-mediated myometrial relaxation, through interaction with actin. pHSP20 represents an important new target for future tocolytic therapy. PMID: 18755793
- AZX100, an analogue of the small heat shock protein, HSP20, reduces TGF-beta1-induced CTGF expression in keloid fibroblasts PMID: 18787533
- Human mutation in the anti-apoptotic heat shock protein 20 abrogates its cardioprotective effects PMID: 18790732
- Here, crystal structures of excised alpha-crystallin domain from rat Hsp20 and that from human alphaB-crystallin show that they form homodimers with a shared groove at the interface by extending a beta sheet. PMID: 19646995
- Report increased levels of phosphorylated Hsp20 in failing hearts. PMID: 19850943
顯示更多
收起更多
-
亞細胞定位:Cytoplasm. Nucleus. Secreted.
-
蛋白家族:Small heat shock protein (HSP20) family
-
數(shù)據(jù)庫鏈接:
Most popular with customers
-
-
YWHAB Recombinant Monoclonal Antibody
Applications: ELISA, WB, IHC, IF, FC
Species Reactivity: Human, Mouse, Rat
-
Phospho-YAP1 (S127) Recombinant Monoclonal Antibody
Applications: ELISA, WB, IHC
Species Reactivity: Human
-
-
-
-
-